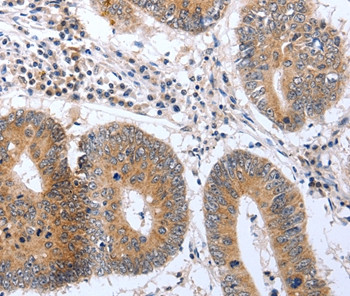
PSPN Antibody in Immunohistochemistry (Paraffin) (IHC (P))

Search
Invitrogen
PSPN Polyclonal Antibody
{{$productOrderCtrl.translations['antibody.pdp.commerceCard.promotion.promotions']}}
{{$productOrderCtrl.translations['antibody.pdp.commerceCard.promotion.viewpromo']}}
{{$productOrderCtrl.translations['antibody.pdp.commerceCard.promotion.promocode']}}: {{promo.promoCode}} {{promo.promoTitle}} {{promo.promoDescription}}. {{$productOrderCtrl.translations['antibody.pdp.commerceCard.promotion.learnmore']}}


Please note: We are reviewing Western blot images included in the antibody testing data in our catalog, including those provided by third parties. Unless expressly labeled or annotated as “raw-unedited”, Western blot images included in the antibody testing data in our catalog may have been edited, optimized or otherwise adjusted for presentation.
产品信息
PA5-50530
种属反应
宿主/亚型
分类
类型
抗原
偶联物
形式
浓度
规格
纯化类型
保存液
内含物
保存条件
运输条件
RRID
产品详细信息
The antibody detects endogenous levels of total Persephin protein.
靶标信息
Persephin is a disulfide-linked, homodimeric, neurotrophic factor structurally related to GDNF, artemin, and neurturin. These proteins belong to the cysteine-knot family of growth factors that assume stable dimeric structures. Persephin signals through a multicomponent receptor system, composed of RET and one of four GFR alpha (alpha1-alpha4) receptors. The GFRalpha4 was first identified in chicken, and was later shown to be the preferential binding subunit for persephin. Persephin promotes the survival of ventral midbrain dopaminergic neurons and motor neurons after sciatic nerve oxotomy, and, like GDNF, promotes ureteric bud branching. However, in contrast to GDNF and neurturin, persephin does not support the survival of peripheral neurons.
仅用于科研。不用于诊断过程。未经明确授权不得转售。